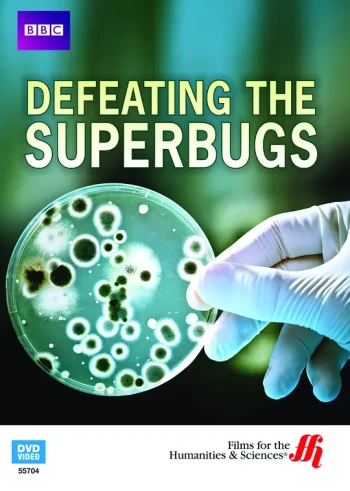
地平线系列：战胜超级病菌

发现"Hun"179部影视剧集
电视剧
全6集

2024/挪威/剧情,喜剧
李镇赫,帕尔·安德斯·诺德维,特赖因·威根,Svein Roger Karlsen,Ragne Grande,科勒·康拉迪,Oddgeir Thune,比约恩·桑德奎斯特,Frank Kjosås,阿克塞尔·博伊姆,Hanne Skille Reitan,Manish Sharma,Benjamin Bakkeid,Tor Ivar Hagen,Nemi Storm,Bjarne Brøndbo,Vetle Røsten Granås,Elisabeth Matheson
电影
HD

2024/美国/动作,惊悚
亚伦·皮埃尔,大卫·丹曼,艾莫里·科恩,Oscar Gale,安娜索菲亚·罗伯,Reid Williams,史蒂夫·齐西斯,Daniel H. Chung,戴纳·李,桑·杰赫,唐·约翰逊,C.J.勒布朗,马修·里默,Brannon Cross,Victor Eli Hugo,詹姆斯·克伦威尔,Chelsea Bryan,阿尔·维森特,特伦斯·罗斯摩尔,Leslie Nipkow
电影
HD中字

2024/英国,赞比亚,爱尔兰/剧情,喜剧
苏珊·沙尔迪,Roy Chisha,Blessings Bhamjee,Chungu Bwalya,玛姬·穆鲁巴,Benson Mumba,Henry B.J. Phiri,伊丽莎白·奇塞拉,Doris Naulapwa,Mary Mulabo,Norah Mwansa,Hildah Mwanza,Febby Lungu,Gillian Sakala,Carol Natasha Mwale,Loveness Nakwiza,Bwalya Chipampata,Faustina Tembo,Justina
电影
HD

2024/美国/剧情
Phoebe-Rae Taylor,卢克·柯比,艾米丽·米切尔,罗丝玛丽·德薇特,朱迪斯·赖特,尼兰·帕尔西潘,Elena Liu Hung,Abbey Jackson,Zander Colbeck-Bhola,Pip McCallan,Sharron Matthews,Cristiano Buchanan,Paulyne Wei,玛丽亚·纳什,Gabriela Francis,考特尼·泰勒,凯瑟琳·麦克纳利,金·赫夫曼,Shaun Shetty,Vicki Kim
动漫
更新至第13话

2023/中国大陆,泰国,韩国/喜剧,动作,动画
马克·汤普森,Barrett Leddy,Samantha Cooper,James Brown Jr.,Valory Pierce,Cat Protano,杰森·格里菲斯,珍妮·横堀,埃里卡·施罗德,本·巴尔马塞达,Adin Rudd,阿曼达·许福德,Brent Mukai,Lucas Schuneman,Tom Wayland,Olivia Vidas,Zuri Washington
电影
HD中字

2022/加拿大,美国/剧情,喜剧
吴恬敏,Kavi Ramachandran Ladnier,Daniel Yoon,Edmund Sim,Destry Miller,Melissa Pond,Chung-Bin Yoon,Taek-Soon Yoon,Jaden Lee,Dougald Park,Jennifer Chang,Kathleen Lancaster,Andrew Lawton,Stephen K. Krespel,Steve Munday
电影
HD中字

电影
HD

2024/美国/惊悚
露西·海尔,维吉尼亚·加德纳,布鲁克·尼文,萨默·萨利姆,Bethany Brown,杰瑞·蒂纳科,杰迪代亚·古达克,Brendan Morgan,Haley Victoria Hunt,RJ·费瑟斯顿豪,劳拉·延加,斯宾塞·博尔格森
电视剧
已完结

2022/泰国/爱情,同性,泰剧
岳凯峰 Hue Chasit Karapim , 普米帕特·派布恩 , 陈家瑨 , 黄书豪 , 王柏佑 Payu Khunnaphat Jaroenchim , 昊天 Virgo Nathapong Sing-On , 苏思南 Park Anantaaj Sods , 李丹尼尔 Danny Bandit Disatharit
电视剧
已完结

2022/美国/喜剧
Michelle Ortiz,Anna Lamadrid,Sandra Marcela Hernandez,Cruz Legaspe Garcia,Mia Hunt,Frankie Quinones,朱莉娅·维拉,劳拉·帕塔拉诺,Chris Estrada,Trevion Twosifix Pleasant,Tina D'Marco,迈克尔·因佩里奥利,诺埃米·冈萨雷斯,多米尼克·培斯,Cuete Yeska,贝尔纳多·巴迪罗,迈克尔·维拉尔,阿尔多·冈萨雷斯
电影
HD中字

1990/美国/喜剧,科幻,恐怖
詹姆斯·洛林兹,Patty Mullen,Carissa Channing,Shirl Bernheim,露易丝·拉塞尔,John Zacherle,Charlotte J. Helmkamp,雪莉·斯托勒,詹妮弗·德罗拉,Lia Chang,Heather Hunter,大卫·李普曼
电视剧
已完结

电影
HD中字

2024/澳大利亚/恐怖
查尔斯·科蒂尔,Dirk Hunter,Amy Ingram,约翰·诺贝尔,Michael Tuahine,Liam Wallace,Tobie Webster,Christian Willis
电影
HD中字

1987/英国/剧情,悬疑,惊悚,情,犯罪,动画,家庭
杰瑞米·布雷特,爱德华·哈德威克,Robin Hunter,罗莎莉·威廉姆斯,詹妮·西格芙,罗莎莉·威廉姆斯,罗纳德·莱西,Emrys James,莉拉·凯,威廉·阿什,基兰·沙阿,戴夫·阿特金斯
电影
正片

1987/美国/情色
梅丽莎·玛兰德兹,珍妮特·利特尔达芙,Siobhan Hunter,比利·迪,赫歇尔·萨维奇,F.M. Bradley,特蕾西·亚当斯,皮特·诺斯,杰米·吉利斯,巴克·亚当斯,罗恩·杰里米,苔米 · 怀特
电视剧
全12集

2024/泰国/爱情,同性
李龙世,Grain Attaphun,Auto Satirapong Raweearamwong,Om Patcharapon,Boss Achitaphon,Tar Aphiwat,Kombam Phanumat,Mab Warthana,Pok Nithikorn,Pe Chatradanai
电影
HD中字

2006/美国/动作,家庭,西部
大卫·卡拉丁 David Carradine 马克·罗斯顿 Mark Rolston Tim Abell Sarah Aldrich Irene Bedard Garret Dillahunt Billy Drago Anthony Hornus
电影
正片

2006/美国/动作,传记,冒险,剧情,战争,情
克里斯蒂安·贝尔,斯蒂夫·扎恩,杰瑞米·戴维斯,扎克·格雷尼尔,马绍尔·贝尔,Lek Chaiyan Chunsuttiwat,扎卡里·卡伯森,克雷格·格利斯,弗朗克西斯·周,帕特·希利,托比·哈斯,克里斯·塔尔曼